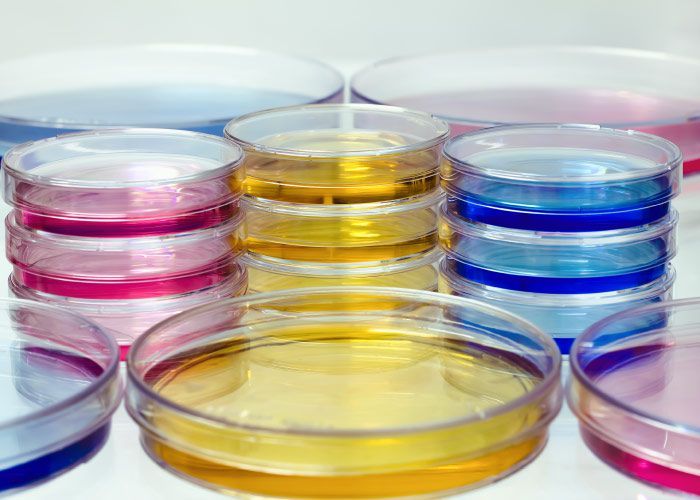
Un montón de placas de Petri llenas de líquidos de diferentes colores.

LABORATORIO DE ANÁLISIS DE ALIMENTOS Y AGUA
Quiénes somos
Aselab Calidad Alimentaria S.L., es una empresa fundada en 1999 y situada en Lucena, Córdoba. Nacimos como asesoría técnica y laboratorio de Alimentos y Aguas para dar cobertura a las empresas alimentarias de la zona centro sur de la provincia de Córdoba. En la actualidad, la empresa ha ampliado no solo sus servicios al cliente sino que ha extendido su campo de trabajo a toda la comunidad autónoma andaluza.
ANÁLISIS DE AGUAS
ANÁLISIS DE AGUASAnálisis de alimentos
ANÁLISIS DE ALIMENTOSAnálisis de alimentos
ANÁLISIS DE SUPERFICIEAnálisis de alimentos
FORMACIÓN DE MANIPULADORESAnálisis de alimentos
CULTIVO Y LEGIONELLAAnálisis de alimentos
PGH Y APPCCNuestra empresa ofrece servicios sanitarios a la industria alimentaria como: proyectos de autocontrol sanitario, análisis de alimentos, aguas, superficies y ambientes y formación de manipuladores de alimentos.
Además ofrecemos nuestros servicios a ayuntamientos y otros colectivos con control de calidad de aguas potables, aguas de piscina así como control de Legionella pneumophilla en torres de refrigeración y otras instalaciones de riesgo.
Para todo ello en Aselab Calidad Alimentaria S.L. contamos con autorización de la Consejería de Agricultura y Pesca de Andalucía, nº A-225-AU, y Registro Oficial de Establecimientos y Servicios Biocidas de Andalucía, nº 0269-AND-350. Además tenemos implantado el Sistema de Gestión ISO 9001 con alcance para análisis de alimentos y aguas, superficie y ambiente e implantación de sistemas de autocontrol sanitario en industrias alimentarias.
La empresa está compuesta por un grupo de profesionales cualificados y en continua formación para adaptarse a las nuevas tecnologías y cuyo mayor objetivo es dar un buen servicio personalizado al cliente con la mejor relación calidad-precio.
AUTORIZACIONES
Visítenos, le esperamos en Lucena, Córdoba.
Informáte sobre
nuestros servicios en análisis de alimentos
contacta con nosotros
Contacta con nosotros
Gracias por contactar con nosotros
En breve atenderemos a su consulta y nos pondremos en contacto con usted en la mayor brevedad posible.
Ups, hubo un error al enviar tu mensaje.
Por favor, inténtelo de nuevo más tarde.












